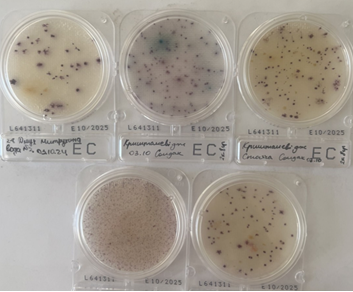

ЗАСІДАННЯ ГУРТКА "САНІТАРНА І ХАРЧОВА МІКРОБІОЛОГІЯ"
У лютому відбулось засідання гуртка "Санітарна і харчова мікробіологія" відповідно до затвердженого календарного плану на навчальний рік.
Студенти-гуртківці відпрацювали методику бактеріологічного дослідження змивів з різних поверхонь за використання хромогенних пластинок Compact Dry (Японія) для кількісного визначення бактерій різних видів.
За результатами дослідження планується підготувати публікацію.
Відпрацювання сучасних методик дослідження в сфері санітарної мікробіології дозволить учасникам у майбутньому застосовувати отримані навички у професійній діяльності під час роботи в лабораторіях відповідного профілю.
Керівник гуртка, доцент Ганна Козловська
